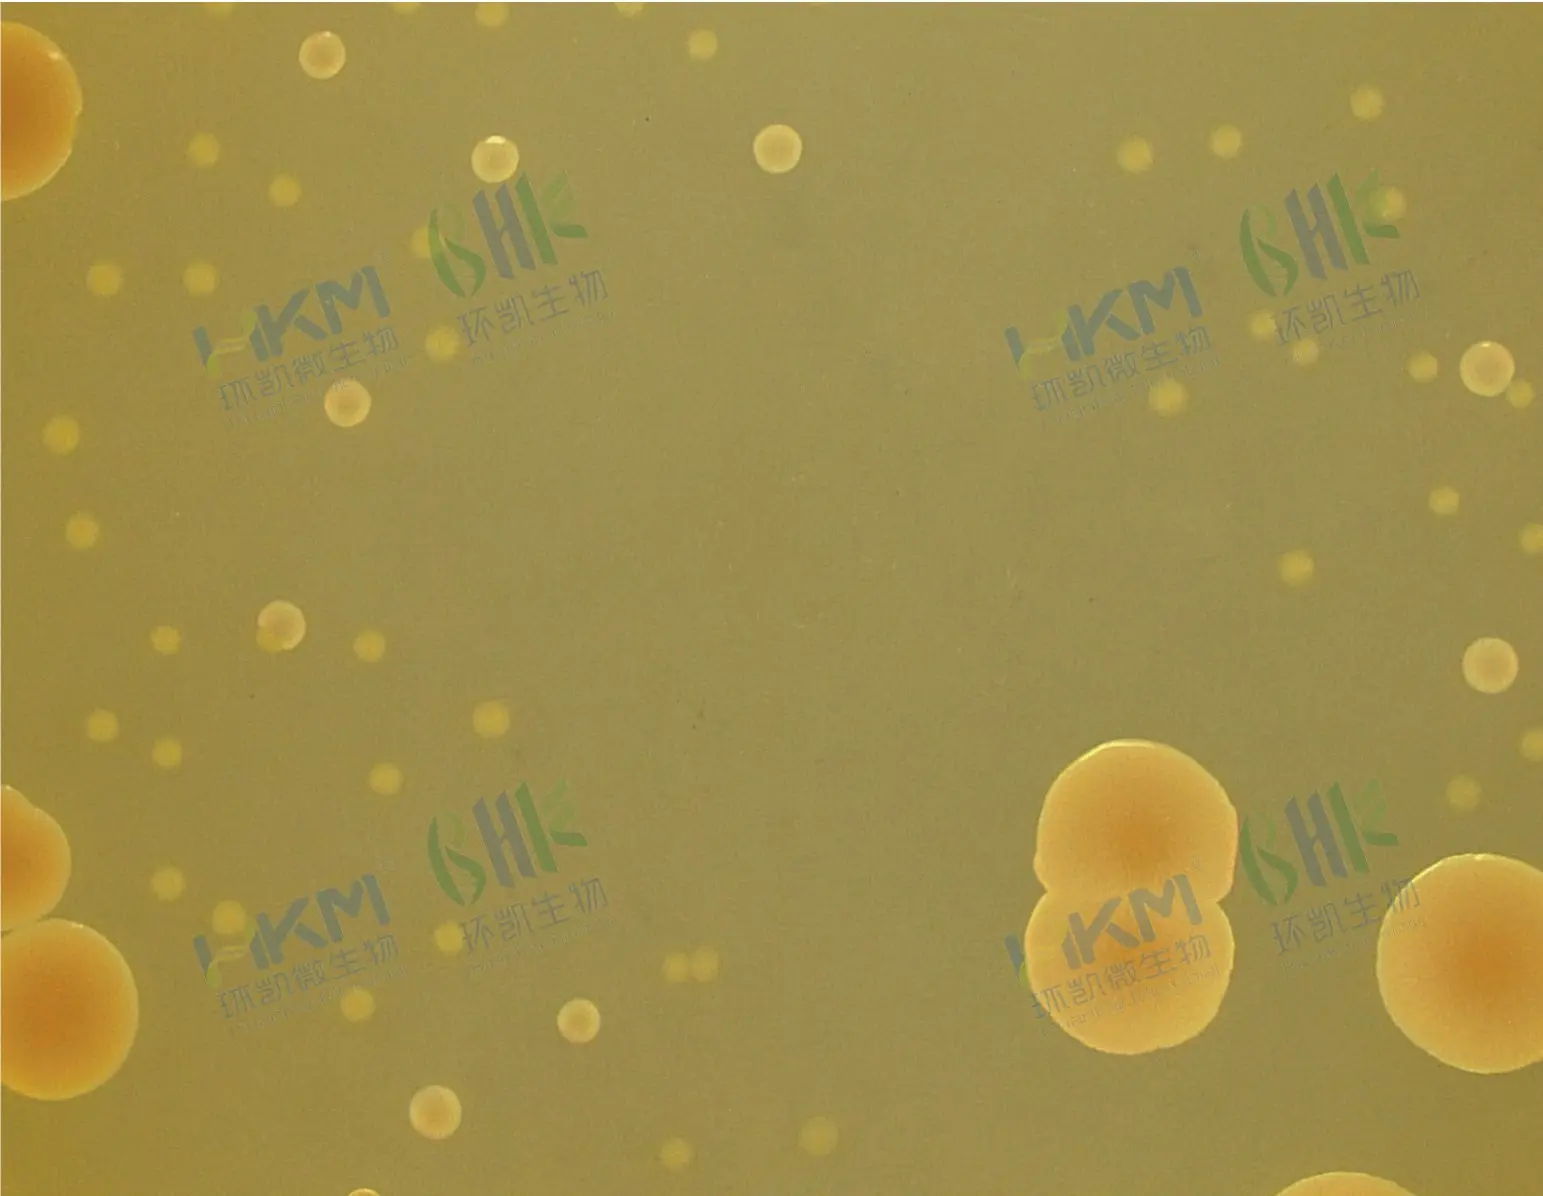
双歧杆菌琼脂培养基质量控制

商品详细
说明书
微生物图册
行业应用
相关论文
产品名称:双歧杆菌琼脂培养基
英文名称:BBL Agar Medium
其它叫法:BBL琼脂培养基
产品用途:用于双歧杆菌的平板计数(GB 4789.34)。
产品编号与包装规格:
| 产品编号 | 产品类型 | 包装规格 |
|---|---|---|
| 027330 | 干粉 | 250g/瓶 |
检验原理:蛋白胨、酵母膏粉提供氮源、维生素、生长因子;葡萄糖为可发酵糖类;吐温-80、肝浸粉、番茄浸粉和半胱氨酸为培养各种双歧杆菌提供生长因子;氯化钠维持均衡的渗透压;琼脂是培养基的凝固剂。
BBL琼脂培养基(双歧杆菌平板计数)配方成分:
| 配方 | 含量(每升) |
|---|---|
| 蛋白胨 | 15.0g |
| 酵母浸粉 | 2.0g |
| 葡萄糖 | 20.0g |
| 可溶性淀粉 | 0.5g |
| 氯化钠 | 5.0g |
| 半胱氨酸 | 0.5g |
| 吐温-80 | 1mL |
| 肝浸粉 | 0.3g |
| 琼脂 | 15.0g |
| 番茄浸粉 | 2.5g |
| 最终pH 6.8±0.1 | |
双歧杆菌琼脂培养基使用方法:称取本品干粉61.8g,加入蒸馏水或去离子水1000mL,加热煮沸至完全溶解,121℃高压灭菌15min,备用。
BBL琼脂培养基质量控制(下列质控菌株接种待测试培养基,36℃±1℃厌氧培养48h~72h结果如下:)
| 指标 | 质控菌株及编号 | 标准值 | 特征性反应 |
|---|---|---|---|
| 生长率 | 两歧双歧杆菌CICC6071 | PR≥0.8 | 圆形凸起,奶油色,边缘整齐光滑 |
| 婴儿双歧杆菌CICC6069 | 圆形凸起,奶油色,边缘整齐光滑 |
储存条件与保质期:贮存于避光、干燥处,用后立即旋紧瓶盖;贮存期三年。
参考文献:GB 4789.34-2016 食品安全国家标准 食品卫生微生物学检验 双歧杆菌检验



















